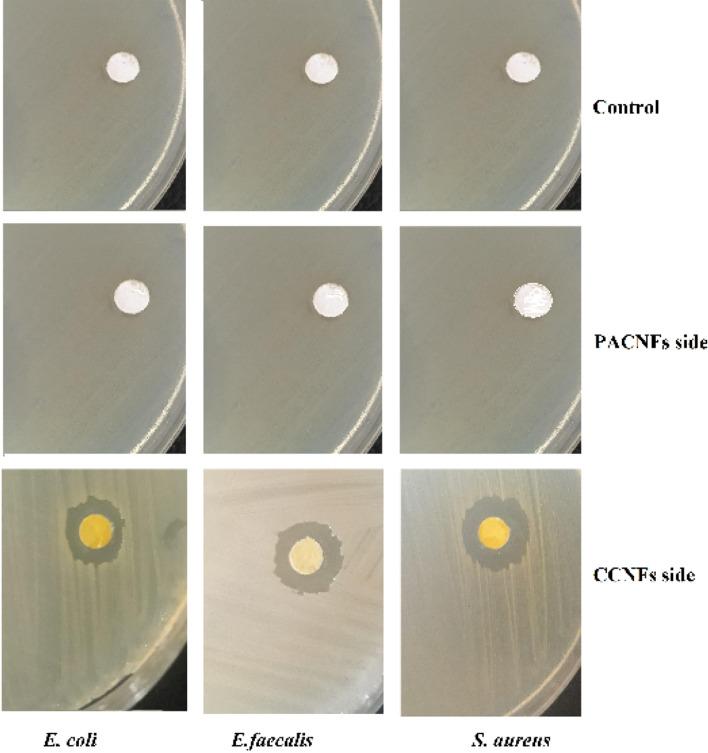
https://cdn.ncbi.nlm.nih.gov/pmc/blobs/02f3/7584591/e139dba4fcd1/41598_2020_75454_Fig7_HTML.jpg

载阿司匹林 PLGA 纳米粒的含纳米纤维不对称胶原/姜黄素膜在引导骨再生中的应用。
Nanofibrous asymmetric collagen/curcumin membrane containing aspirin-loaded PLGA nanoparticles for guided bone regeneration.
机构信息
Department of Oral and Maxillofacial Surgery, Faculty of Dentistry, Tabriz University of Medical Sciences, Tabriz, Iran.
Department of Clinical Sciences, Faculty of Veterinary Medicine, University of Tabriz, Tabriz, Iran.
出版信息
Sci Rep. 2020 Oct 23;10(1):18200. doi: 10.1038/s41598-020-75454-2.
The goal of the current study was to develop an asymmetric guided bone regeneration (GBR) membrane benefiting from curcumin and aspirin. The membrane was prepared using electrospinning technique and then was physic-chemically characterized by the conventional methods. The release profile of aspirin from the prepared membrane was also measured by ultraviolet spectrophotometry. Also, the antibacterial activities of the membrane was evaluated. We also assessed the in vitro effects of the prepared membrane on the biocompatibility and osteogenic differentiation of dental pulp stem cells (DPSCs), and evaluated in vivo bone regeneration using the prepared membrane in the defects created in both sides of the dog's jaw by histology. The results from the characterization specified that the membrane was successfully prepared with monodispersed nanosized fibers, uniform network shaped morphology, negative surface charge and sustained release platform for aspirin. The membrane also showed antimicrobial effects against all tested bacteria. The presence of curcumin and aspirin in the asymmetric membrane enhanced osteogenic potential at both transcriptional and translational levels. The results of the animal test showed that the test area was completely filled with new bone after just 28 days, while the commercial membrane area remained empty. There was also a soft tissue layer above the new bone area in the test side. We suggested that the prepared membrane in this work could be used as a GBR membrane to keep soft tissue from occupying bone defects in GBR surgeries. Besides, the surgeries can be benefited from antibacterial activities and bone healing effects of this novel GBR membrane while, simultaneously, promoting bone regeneration.
本研究旨在开发一种受益于姜黄素和阿司匹林的不对称引导骨再生(GBR)膜。该膜采用静电纺丝技术制备,然后通过常规方法进行物理化学表征。通过紫外分光光度法测量了阿司匹林从制备的膜中的释放情况。此外,还评估了膜的抗菌活性。我们还评估了制备的膜对牙髓干细胞(DPSCs)的生物相容性和成骨分化的体外影响,并通过组织学评估了在狗的下颌两侧创建的缺陷中使用制备的膜的体内骨再生情况。表征结果表明,成功制备了具有单分散纳米纤维、均匀网络状形态、负表面电荷和阿司匹林持续释放平台的膜。该膜还对所有测试的细菌表现出抗菌作用。不对称膜中姜黄素和阿司匹林的存在增强了成骨潜力,在转录和翻译水平上均有提高。动物试验的结果表明,仅 28 天后,试验区域就完全被新骨填满,而商业膜区域仍然是空的。在试验侧的新骨区域上方还有一层软组织。我们建议,在 GBR 手术中,该工作中制备的膜可用作 GBR 膜,以防止软组织占据骨缺损。此外,该新型 GBR 膜的抗菌活性和骨愈合效果可使手术受益,同时促进骨再生。